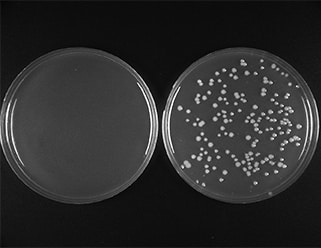

Serial cloner cohesive ends series#
Importantly, the responses elicited in each series paralleled changes in theĮxperimental protocols and may help to explain the variation in magnetic behaviours. (Series 1), independent of the trained direction, and similar to spontaneous magnetic alignment responses in other vertebrates, or exhibited learned magnetic compass orientation in the direction awayįrom (Series 2) or towards (Series 3) the sheltered end of the magnetic axis they had been exposed toĭuring the training period. Magnetic directions, mice either positioned nests along a fixed northeastesouthwest magnetic axis Of three similar nest-building experiments in which mice were trained to construct nests in one of four Mice, we provide evidence for multiple spatial responses to magnetic cues in the same species. motivational, physiological and/or environmental. magnetic orientation may be context dependent and expressed in the same species underĭifferent conditions, e.g. Magnetic compass responses or spontaneous magnetic orientation). However, it remains to beĭetermined whether the type of magnetic response is species specific (i.e. Previous studies have shown that mammals exhibit two distinct forms of magnetic behaviour: spontaneous magnetic alignment and learned magnetic compass orientation. I also identify three factors that influence whether or not a diplomatic performance succeeds in making those who are represented act: recognition by other international actors, practical competence, and the alignment of the represented. Tracing how Kosovo Albanians and their international supporters staged Kosovo's diplomatic performance, and how the Yugoslav/Serbian delegation tried to undermine it, I demonstrate that diplomatic representation can indeed generate agency. Equipped with this conceptual toolkit, I subsequently turn to the story of Kosovo's representation at the Rambouillet conference held in 1999. Taking cue from Bruno Latour's and Lisa Disch's writings on political representation, I then suggest an alternative understanding of diplomacy that takes its performative character seriously. Therefore, to clarify what is at stake in the theoretical debate, I begin with a systematic discussion of how IR has conceived of diplomatic representation. role of diplomacy in the constitution of agency. Thus far, however, the academic discipline of International Relations (IR) has largely failed to acknowledge the.
It demonstrates that, in the world of diplomacy, entities like 'Kosovo' can act only when they are carefully staged. This article traces how Kosovo came to agree to the Rambouillet accords, with the aim of exploring the nexus between diplomatic representation and international agency. The emotional state and shopping value created by the shopping environment were found to influence enjoyment of shopping, willingness to talk to salespeople, revisit intentions, and tendency to spend more money and time than originally planned. This research explored the relationships between the shopping environment and tourists’ emotions, shopping values and approach behaviours. The environment of shopping locations at destination must be pleasing and induce approach behaviours for the retail sector to be successful. If macroenvironment is not attractive and inviting, the rest of the in-store atmosphere may not matter.

Exterior environment in shopping districts at destinations deserves attention in that macroclimate is the first set of cues. In this context, the shopping environment itself may become part of the tourist's experience influencing subsequent shopping behaviours and evaluations. Research and anecdotal evidence suggests that satisfaction from shopping is not necessarily derived from acquiring goods. These two complimentary techniques, both involving use of the long PCR paired with restriction digestion, have potential application in any laboratory in which PCR is performed. Restriction digestion performed prior to long PCR amplification can be used to selectively suppress the amplification of members of families of closely related DNA sequences, thereby making it possible to selectively amplify one of a group of highly homologous sequences. The same primers used to perform the long PCR amplification can be used as probes to perform restriction mapping of the DNA fragment amplified. This article describes two novel applications of the long PCR technique, one which simplifies restriction mapping and another which enhances amplification specificity and yield. Applications for PCR have been extended significantly by the development of "long" PCR, a technique that makes it possible to amplify DNA fragments up to 40 kb in length. The polymerase chain reaction (PCR) is the most widely used technique for the study of DNA.
